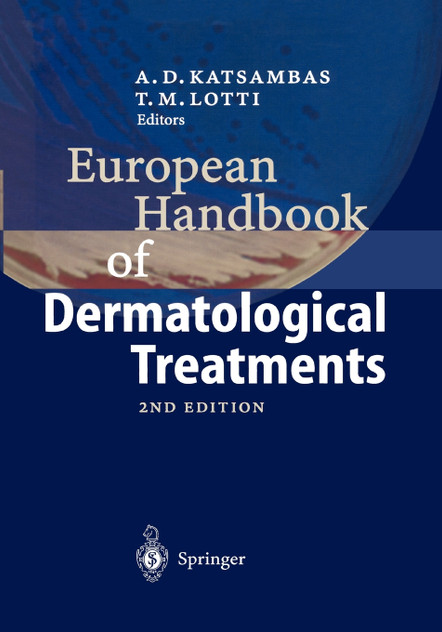

European Handbook of Dermatological Treatments
The Handbook of Systemic Drug Treatment in Dermatology helps prescribers and patients make rational decisions about drug treatment while considering known risks and potential unwanted effects. Written for dermatologists, family practitioners, pharmacists and specialist nurses, this completely revised and updated third edition of a bestseller provides an accessible and concise aid to prescribing and monitoring systemic dermatologic therapy. For each drug or drug class, the book lists its classification, mode of action, formulations, dosages, suggested regimens, contraindications, important drug interactions, adverse effects, patient information, and more. This third edition includes new classes of drugs as well as information on updated guidelines for prescribing and monitoring established drugs.
FROM REVIEWS OF PREVIOUS EDITIONS
"This updated edition includes new arrivals... Quite simply, it is indispensable! I have it with me in every clinic and often refer to it in discussions with pharmacists (who have been known to borrow my copy and forget to return it)." Dermatology in Practice
"... an outstanding resource that helps to alleviate worrying by providing precise guidelines and advice in managing our most infirm patients who require these medications." SkinMed
Discover your next great read at BookLoop, Australiand online bookstore offering a vast selection of titles across various genres and interests. Whether you're curious about what's trending or searching for graphic novels that captivate, thrilling crime and mystery fiction, or exhilarating action and adventure stories, our curated collections have something for every reader. Delve into imaginative fantasy worlds or explore the realms of science fiction that challenge the boundaries of reality. Fans of contemporary narratives will find compelling stories in our contemporary fiction section. Embark on epic journeys with our fantasy and science fiction titles,
Explore our new releases for the most recent additions in romance books, fantasy books, graphic novels, crime and mystery books, science fiction books as well as biographies, cookbooks, self help books, tarot cards, fortunetelling and much more. With titles covering current trends, booktok and bookstagram recommendations, and emerging authors, BookLoop remains your go-to local australian bookstore for buying books online across all book genres.
Stay updated with the literary world by browsing our trending books, featuring the latest bestsellers and critically acclaimed works. Explore titles from popular brands like Minecraft, Pokemon, Star Wars, Bluey, Lonely Planet, ABIA award winners, Peppa Pig, and our specialised collection of ADHD books. At BookLoop, we are committed to providing a diverse and enriching reading experience for all.
If you have any questions before making a purchase chat with our online operators to get more information.
or find our Questions & Answers